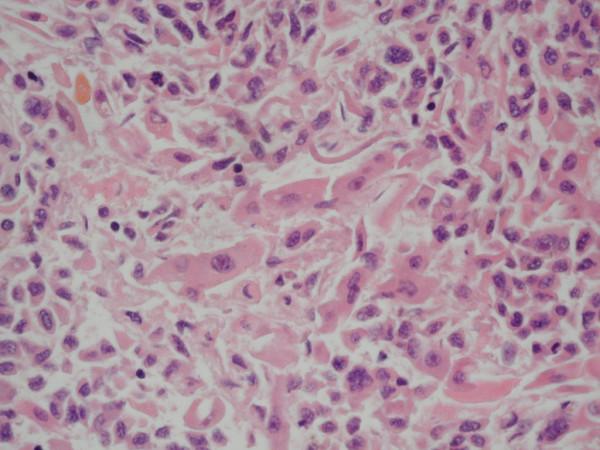
https://cdn.ncbi.nlm.nih.gov/pmc/blobs/b493/1192792/81d3af814b16/1471-2407-5-67-1.jpg

急性肝衰竭及继发于转移性黑色素瘤肝置换的多系统器官衰竭。
Acute hepatic failure and multi-system organ failure secondary to replacement of the liver with metastatic melanoma.
作者信息
Kaplan Gilaad G, Medlicott Shaun, Culleton Bruce, Laupland Kevin B
机构信息
Department of Medicine, University of Calgary and Calgary Health Region, Calgary, Alberta, Canada.
出版信息
BMC Cancer. 2005 Jun 30;5:67. doi: 10.1186/1471-2407-5-67.
BACKGROUND
Metastatic malignant melanoma to the liver resulting in fulminant hepatic failure is a rare occurrence.
CASE PRESENTATION
A 46 year old man presented to hospital with massive hepatomegaly, elevated liver enzymes and increased lactate three weeks following resection of a malignant melanoma from his shoulder (Clark level 5). Initially stable, he decompensated 24 to 48 hours subsequent to presentation with respiratory failure requiring mechanical ventilation, distributive shock requiring high dose vasopressor infusion, coagulopathy refractory to plasma infusion, progressive rise in liver enzymes and severe metabolic abnormalities including hyperkalemia, acidosis, hyperphosphatemia, hyperuricemia and hypocalcemia. Refractory to aggressive physiologic support he received palliation. Autopsy revealed >80% liver infiltration by metastatic malignant melanoma.
CONCLUSION
We report a case of fulminant hepatic failure secondary to metastatic malignant melanoma infiltration of the liver.
背景
转移性恶性黑色素瘤累及肝脏导致暴发性肝衰竭实属罕见。
病例介绍
一名46岁男性,在肩部恶性黑色素瘤(克拉克5级)切除术后三周,因肝脏肿大、肝酶升高和乳酸水平升高入院。最初病情稳定,但入院后24至48小时病情恶化,出现呼吸衰竭需要机械通气、分布性休克需要高剂量血管活性药物输注、输注血浆难以纠正的凝血障碍、肝酶进行性升高以及严重代谢异常,包括高钾血症、酸中毒、高磷血症、高尿酸血症和低钙血症。尽管给予积极的生理支持,但病情仍难以控制,最终接受了姑息治疗。尸检显示肝脏被转移性恶性黑色素瘤浸润达80%以上。
结论
我们报告了一例因转移性恶性黑色素瘤浸润肝脏继发暴发性肝衰竭的病例。